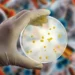
Foto: Getty Images

Os futuros do minério de ferro em Dalian caíram nesta quinta-feira (17), atingindo seu nível mais baixo em mais de duas semanas, pressionados pela falta de novos estímulos na China, principal consumidor, enquanto o aumento da oferta de empresas importantes de mineração também pesou sobre o mercado. O contrato de janeiro do minério de ferro mais negociado na Bolsa de Commodities de Dalian encerrou as negociações com queda de 5,99%, a 746,0 iuanes (US$ 104,74) a tonelada métrica, atingindo seu nível mais fraco desde 30 de setembro.
O minério de ferro de referência para novembro recuava 5% na Bolsa de Cingapura, para 99,5 dólares a tonelada. As expectativas de estímulo fiscal na China foram frustradas depois que o Ministério das Finanças falhou em expandir além do apoio de crédito já existente às incorporadoras imobiliárias que estão concluindo projetos de construção inacabados, disse Cameron Law, analista de commodities da Navigate Commodities.
“Continuamos altamente céticos em relação às contribuições positivas líquidas que essas medidas terão sobre o aço chinês e o consumo subjacente de minério de ferro no médio prazo, uma vez que os novos projetos de construção, que são o principal impulsionador da demanda por aço, continuarão a ser mantidos sob rédea curta”, disse Law.
A China disse que ampliará uma lista de projetos habitacionais elegíveis para financiamento e aumentará os empréstimos bancários para esses empreendimentos para 4 trilhões de iuanes (562 bilhões de dólares).
Analistas disseram que a entrevista sobre a política habitacional anunciou poucas políticas incrementais para aumentar a demanda por imóveis.
Enquanto isso, as perspectivas de uma oferta global mais firme também pesaram sobre o mercado de minério de ferro.
A BHP, a maior mineradora de capital aberto do mundo, superou as estimativas de produção de minério de ferro do primeiro trimestre, enquanto a Vale divulgou sua maior produção trimestral de minério de ferro desde 2018.